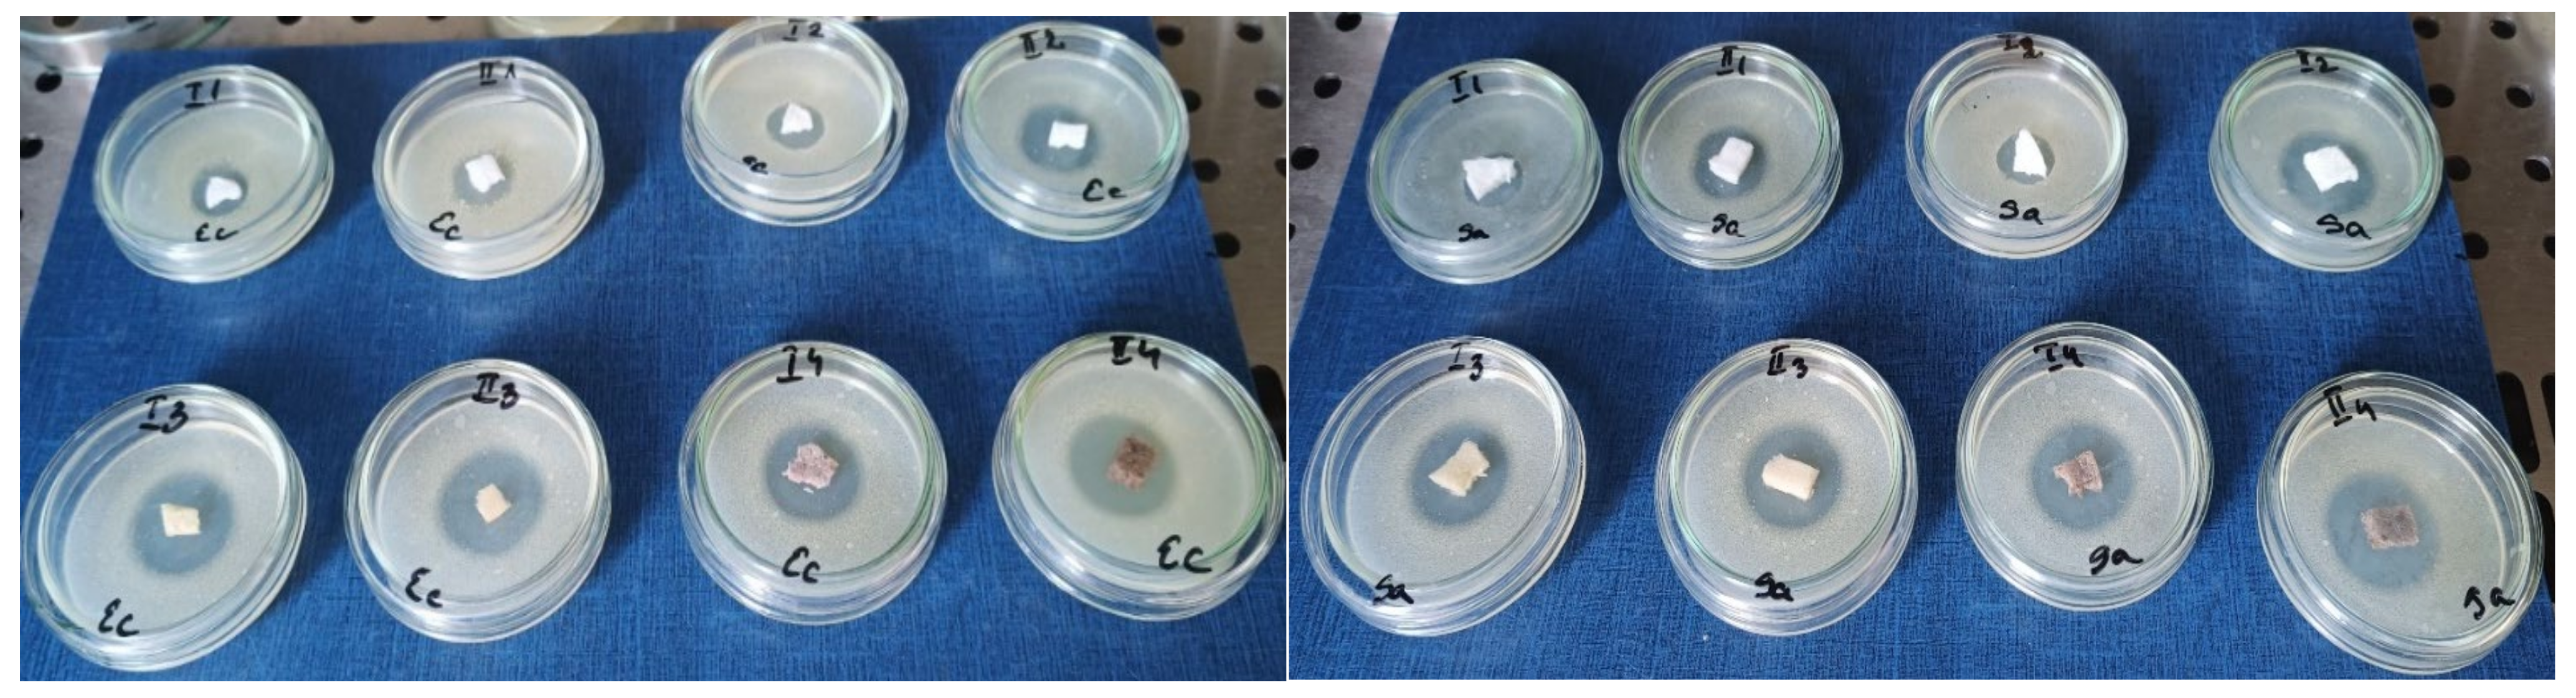
Materials 18 00998 g014

The Role of Crosslinking Agents in the Development of Collagen–Hydroxyapatite Composite Materials for Bone Tissue Engineering
Abstract
1. Introduction
2. Materials and Methods
2.1. Obtaining the Freeze-Dried Coll/HAp Composite Materials
2.2. Characterization Techniques
2.2.1. Water Absorption of the Composite Materials
2.2.2. Enzymatic Degradation
2.2.3. Scanning Electron Microscopy (SEM) and ImageJ Porosity Determination
2.2.4. Fourier Transform Infrared Spectroscopy (FTIR)
2.2.5. X-Ray Diffract Ion (XRD)
2.2.6. Thermogravimetric Analysis
2.2.7. Mechanical Testing
2.2.8. Antimicrobial Activity
3. Results and Discussion
3.1. Water Uptake Evaluation of Coll/HAp Sponges
3.2. Enzymatic Degradation of Coll/HAp Sponges
3.3. Scanning Electron Microscopy (SEM) and Energy Dispersive X-Ray Spectroscopy (EDX) Characterization
3.4. FTIR Spectroscopy and Microscopy
3.5. X-Ray Diffraction (XRD)
3.6. Thermogravimetric Analysis
3.7. Mechanical Testing
3.8. Antimicrobial Activity
4. Conclusions
Author Contributions
Funding
Institutional Review Board Statement
Informed Consent Statement
Data Availability Statement
Acknowledgments
Conflicts of Interest
Appendix A
| Time | I.1 | SD | I.2 | SD | I.3 | SD | I.4 | SD |
|---|---|---|---|---|---|---|---|---|
| 1 h | 32.3854 | 1.8455 | 27.3102 | 1.3949 | 33.9259 | 2.8628 | 22.6202 | 0.9752 |
| 2 h | 36.5731 | 1.6855 | 28.1749 | 1.316 | 34.1771 | 1.6804 | 25.4603 | 3.2604 |
| 4 h | 36.0146 | 2.8666 | 28.1265 | 1.8716 | 35.4709 | 1.9908 | 25.2210 | 3.2299 |
| 24 h | 34.5932 | 1.5981 | 27.686 | 2.6646 | 35.8255 | 0.7345 | 25.6504 | 3.1545 |
| 48 h | 36.8161 | 4.6903 | 30.9512 | 1.6697 | 37.9903 | 0.5637 | 28.3459 | 0.8751 |
| Time | II.1 | SD | II.2 | SD | II.3 | SD | II.4 | SD |
|---|---|---|---|---|---|---|---|---|
| 1 h | 23.8703 | 3.4107 | 22.9792 | 3.6308 | 25.3585 | 1.2655 | 28.9006 | 1.3819 |
| 2 h | 23.0132 | 4.6984 | 25.0582 | 3.0948 | 24.2272 | 1.3135 | 30.8481 | 4.7348 |
| 4 h | 24.7849 | 1.6964 | 25.7003 | 2.5981 | 22.6525 | 1.6317 | 29.3223 | 1.0392 |
| 24 h | 25.582 | 2.6111 | 23.9612 | 3.8225 | 23.1907 | 0.8352 | 30.2634 | 1.5926 |
| 48 h | 22.6094 | 1.6101 | 26.8037 | 1.3471 | 23.5970 | 0.3977 | 29.9090 | 1.5276 |
References
- Yang, B.-C.; Lee, J.-W.; Ju, C.-P.; Chern Lin, J.-H. Physical/Chemical Properties and Resorption Behavior of a Newly Developed Ca/P/S-Based Bone Substitute Material. Materials 2020, 13, 3458. [Google Scholar] [CrossRef] [PubMed]
- Bone Grafts And Substitutes Market Size, Share & Trends Analysis Report By Material Type (Allograft, Synthetic), By Application (Spinal Fusion, Dental), By Region, And Segment Forecasts, 2025–2030. Available online: https://www.grandviewresearch.com/industry-analysis/bone-grafts-substitutes-market# (accessed on 24 December 2024).
- Georgeanu, V.A.; Gingu, O.; Antoniac, I.V.; Manolea, H.O. Current Options and Future Perspectives on Bone Graft and Biomaterials Substitutes for Bone Repair, from Clinical Needs to Advanced Biomaterials Research. Appl. Sci. 2023, 13, 8471. [Google Scholar] [CrossRef]
- Misaghi, A.; Goldin, A.; Awad, M.; Kulidjian, A.A. Osteosarcoma: A comprehensive review. SICOT-J 2018, 4, 12. [Google Scholar] [CrossRef] [PubMed]
- Younger, E.M.; Chapman, M.W. Morbidity at bone graft donor sites. J. Orthop. Trauma 1989, 3, 192–195. [Google Scholar] [CrossRef] [PubMed]
- Baldwin, P.; Li, D.J.; Auston, D.A.; Mir, H.S.; Yoon, R.S.; Koval, K.J. Autograft, Allograft, and Bone Graft Substitutes: Clinical Evidence and Indications for Use in the Setting of Orthopaedic Trauma Surgery. J. Orthop. Trauma 2019, 33, 203–213. [Google Scholar] [CrossRef] [PubMed]
- Einhorn, T.A. The cell and molecular biology of fracture healing. Clin. Orthop. Relat. Res. 1998, 355, S7–S21. [Google Scholar] [CrossRef]
- Parackal, S.T.; Paul, J.; Dlima, J.; Darshana, P.V.; Pyas, A.M.; Jiffry, C.A.S.M.; Nair, S.K. Hydroxyapatite Composites in Tissue Engineering [Internet]. Biomedical Engineering; IntechOpen: Rijeka, Croatia, 2024. [Google Scholar] [CrossRef]
- Wu, M.; Cronin, K.; Crane, J.S. Biochemistry, Collagen Synthesis; [Updated 2023 Sep 4]; StatPearls [Internet]; StatPearls Publishing: Treasure Island, FL, USA, 2024. Available online: https://www.ncbi.nlm.nih.gov/books/NBK507709/ (accessed on 24 September 2024).
- Bellis, S.L. Advantages of RGD peptides for directing cell association with biomaterials. Biomaterials 2011, 32, 4205–4210. [Google Scholar] [CrossRef] [PubMed] [PubMed Central]
- Shi, H.; Zhou, Z.; Li, W.; Fan, Y.; Li, Z.; Wei, J. Hydroxyapatite Based Materials for Bone Tissue Engineering: A Brief and Comprehensive Introduction. Crystals 2021, 11, 149. [Google Scholar] [CrossRef]
- Winkler, T.; Sass, F.A.; Duda, G.N.; Schmidt-Bleek, K. A review of biomaterials in bone defect healing, remaining shortcomings and future opportunities for bone tissue engineering: The unsolved challenge. Bone Jt. Res. 2018, 7, 232–243. [Google Scholar] [CrossRef]
- Aulakh, T.S.; Jayasekera, N.; Kuiper, J.H.; Richardson, J.B. Long-term clinical outcomes following the use of synthetic hydroxyapatite and bone graft in impaction in revision hip arthroplasty. Biomaterials 2009, 30, 1732–1738. [Google Scholar] [CrossRef]
- Ielo, I.; Calabrese, G.; De Luca, G.; Conoci, S. Recent Advances in Hydroxyapatite-Based Biocomposites for Bone Tissue Regeneration in Orthopedics. Int. J. Mol. Sci. 2022, 23, 9721. [Google Scholar] [CrossRef] [PubMed] [PubMed Central]
- Meagher, M.J.; Weiss-Bilka, H.E.; Best, M.E.; Boerckel, J.D.; Wagner, D.R.; Roeder, R.K. Acellular hydroxyapatite-collagen scaffolds support angiogenesis and osteogenic gene expression in an ectopic murine model: Effects of hydroxyapatite volume fraction. J. Biomed. Mater. Res.-Part A 2016, 104, 2178–2188. [Google Scholar] [CrossRef]
- Helgeland, E.; Rashad, A.; Campodoni, E.; Goksøyr, Ø.; Pedersen, T.; Sandri, M.; Rosén, A.; Mustafa, K. Dual-crosslinked 3D printed gelatin scaffolds with potential for temporomandibular joint cartilage regeneration. Biomed. Mater. 2021, 16, 035026. [Google Scholar] [CrossRef] [PubMed]
- Jayachandran, B.; Parvin, T.N.; Alam, M.M.; Chanda, K.; Mm, B. Insights on Chemical Crosslinking Strategies for Proteins. Molecules 2022, 27, 8124. [Google Scholar] [CrossRef] [PubMed] [PubMed Central]
- Ficai, A.; Andronescu, E.; Voicu, G.; Ghitulica, C.; Vasile, B.S.; Ficai, D.; Trandafir, V. Self-assembled collagen/hydroxyapatite composite materials. Chem. Eng. J. 2010, 160, 794–800. [Google Scholar] [CrossRef]
- Olde Damink, L.H.H.; Dijkstra, P.J.; Van Luyn, M.J.A.; Van Wachem, P.B.; Nieuwenhuis, P.; Feijen, J. Glutaraldehyde as a crosslinking agent for collagen-based biomaterials. J. Mater. Sci. Mater. Med. 1995, 6, 460–472. [Google Scholar] [CrossRef]
- Rebelo, R.; Fernandes, M.; Fangueiro, R. Biopolymers in Medical Implants: A Brief Review. Procedia Eng. 2017, 200, 236–243. [Google Scholar] [CrossRef]
- Wu, Y.; Chen, S.; Luo, P.; Deng, S.; Shan, Z.; Fang, J.; Liu, X.; Xie, J.; Liu, R.; Wu, S.; et al. Optimizing the bio-degradability and biocompatibility of a biogenic collagen membrane through cross-linking and zinc-doped hydroxyapatite. Acta Biomater. 2022, 143, 159–172. [Google Scholar] [CrossRef]
- Rahman, M.S.; Rana, M.M.; Spitzhorn, L.-S.; Akhtar, N.; Hasan, M.Z.; Choudhury, N.; Fehm, T.; Czernuszka, J.T.; Adjaye, J.; Asaduzzaman, S.M. Fabrication of Biocompatible Porous Scaffolds Based on Hydroxyapatite/Collagen/Chitosan Composite for Restoration of Defected Maxillofacial Mandible Bone. Prog. Biomater. 2019, 8, 137–154. [Google Scholar] [CrossRef]
- Sobczak-Kupiec, A.; Drabczyk, A.; Florkiewicz, W.; Głąb, M.; Kudłacik-Kramarczyk, S.; Słota, D.; Tomala, A.; Tyliszczak, B. Review of the Applications of Biomedical Compositions Containing Hydroxyapatite and Collagen Modified by Bioactive Components. Materials 2021, 14, 2096. [Google Scholar] [CrossRef]
- Yu, Y.; Xu, S.; Li, S.; Pan, H. Genipin-cross-linked hydrogels based on biomaterials for drug delivery: A review. Biomater. Sci. 2021, 9, 1583–1597. [Google Scholar] [CrossRef] [PubMed]
- Liu, Z.; Zhou, Q.; Zhu, J.; Xiao, J.; Wan, P.; Zhou, C.; Huang, Z.; Qiang, N.; Zhang, W.; Wu, Z.; et al. Using genipin-crosslinked acellular porcine corneal stroma for cosmetic corneal lens implants. Biomaterials 2012, 33, 7336–7346. [Google Scholar] [CrossRef] [PubMed]
- Hurtado, L.H.; Nejati, M.; Fang, Y.; Guo, B.; Jiménez-Quero, A.; Capezza, A.; Sabino, M. New sources of genipin-rich substances for crosslinking future manufactured bio-based materials. RSC Sustain. 2024, 2, 125–138. [Google Scholar] [CrossRef]
- Ma, X.; He, Z.; Han, F.; Zhong, Z.; Chen, L.; Li, B. Preparation of collagen/hydroxyapatite/alendronate hybrid hydrogels as potential scaffolds for bone regeneration. Colloids Surf. B Biointerfaces 2016, 143, 81–87. [Google Scholar] [CrossRef]
- Scialla, S.; Gullotta, F.; Izzo, D.; Palazzo, B.; Scalera, F.; Martin, I.; Sannino, A.; Gervaso, F. Genipin-crosslinked collagen scaffolds inducing chondrogenesis: A mechanical and biological characterization. J. Biomed. Mater. Res. Part A 2022, 1–14, 1372–1385. [Google Scholar] [CrossRef]
- Huertas-Bello, M.; Cuéllar-Sáenz, J.A.; Rodriguez, C.N.; Cortés-Vecino, J.A.; Navarrete, M.L.; Avila, M.Y.; Koudouna, E. A Pilot Study to Evaluate Genipin in Staphylococcus aureus and Pseudomonas aeruginosa Keratitis Models: Modulation of Pro-Inflammatory Cytokines and Matrix Metalloproteinases. Int. J. Mol. Sci. 2023, 24, 6904. [Google Scholar] [CrossRef]
- King, A.M.Y.; Young, G. Characteristics and Occurrence of Phenolic Phytochemicals. J. Am. Diet. Assoc. 1999, 99, 213–218. [Google Scholar] [CrossRef]
- Kaczmarek, B. Tannic Acid with Antiviral and Antibacterial Activity as A Promising Component of Biomaterials—A Minireview. Materials 2020, 13, 3224. [Google Scholar] [CrossRef]
- Erel-Unal, I.; Sukhishvili, S.A. Hydrogen-Bonded Multilayers of a Neutral Polymer and a Polyphenol. Macromolecules 2008, 41, 3962–3970. [Google Scholar] [CrossRef]
- Chen, C.; Yang, H.; Yang, X.; Ma, Q. Tannic acid: A crosslinker leading to versatile functional polymeric networks: A review. RSC Adv. 2022, 12, 7689–7711. [Google Scholar] [CrossRef]
- Kaczmarek, B.; Sionkowska, A.; Otrocka-Domagała, I.; Polkowska, I. In vivo studies of novel saffolds with tannic acid addition. Polym. Degrad. Stab. 2018, 158, 26–30. [Google Scholar] [CrossRef]
- Dong, G.; Liu, H.; Yu, X.; Zhang, X.; Lu, H.; Zhou, T.; Cao, J. Antimicrobial and anti-biofilm activity of tannic acid against Staphylococcus aureus. Nat. Prod. Res. 2017, 32, 2225–2228. [Google Scholar] [CrossRef]
- Albu, M.G. Collagen Gels and Matrices for Biomedical Applications; Lambert Academic Publishing: Saarbrücken, Germany, 2011. [Google Scholar]
- Albu Kaya, M.G.; Ferdes, M.; Kaya, D.A.; Ghica, M.V.; Titorencu, I.; Popa, L.; Albu, L. Collagen wound dressings with anti-inflamatory activity. Mol. Cryst. Liq. Cryst. 2012, 555, 271–279. [Google Scholar] [CrossRef]
- ASTM D695-15; Standard Test Method for Compressive Properties of Rigid Plastics. ASTM International: West Conshohocken, PA, USA, 2015.
- Vladu, A.; Marin, S.; Neacsu, I.; Trusca, R.; Kaya, M.; Kaya, D.; Popa, A.-M.; Poiană, C.; Cristescu, I.; Orlov, C.; et al. Spongious fillers based on collagen-hydroxyapatite-eugenol acetate with therapeutic potential in bone cancer. Farmacia 2020, 68, 313–321. [Google Scholar] [CrossRef]
- Riaz, T.; Zeeshan, R.; Zarif, F.; Ilyas, K.; Muhammad, N.; Safi, S.Z.; Rahim, A.; Rizvi, S.A.A.; Rehman, I.U. FTIR analysis of natural and synthetic collagen. Appl. Spectrosc. Rev. 2018, 53, 703–746. [Google Scholar] [CrossRef]
- Mendes, L.C. In Situ Hydroxyapatite Synthesis: Influence of Collagen on Its Structural and Morphological Characteristic. Mater. Sci. Appl. 2012, 3, 580–586. [Google Scholar]
- Fibryanto, E.; Amanda, H.G. Characterization of Nano-Hydroxyapatite–Collagen and Epigallocatechin-3-Gallate (EGCG) Composites by Scanning Electron Microscopy-Energy Dispersive Spectroscopy (SEM-EDS), X-Ray Diffraction (XRD), and Fourier Transform Infrared (FTIR) Spectroscopy. Sci. Dent. J. 2022, 6, 80–86. [Google Scholar] [CrossRef]
- Adam, M.; Ganz, C.; Xu, W.; Sarajian, H.R.; Götz, W.; Gerber, T. In vivo and in vitro investigations of a nanostructured coating material—A preclinical study. Int. J. Nanomed. 2014, 9, 975–984. [Google Scholar] [CrossRef]
- Spevak, L.; Flach, C.R.; Hunter, T.; Mendelsohn, R.; Boskey, A. Fourier transform infrared spectroscopic imaging parameters describing acid phosphate substitution in biologic hydroxyapatite. Calcif. Tissue Int. 2013, 92, 418–428. [Google Scholar] [CrossRef]
- Srivatsan, K.V.; Duraipandy, N.; Lakra, R.; Ramamurthy, U.; Korrapati, P.S.; Kiran, M.S. Nano-caged shikimate as a multi-site cross-linker of collagen for biomedical applications. RSC Adv. 2015, 5, 22106–22116. [Google Scholar] [CrossRef]
- Zhang, X.; Xu, S.; Shen, L.; Li, G. Factors affecting thermal stability of collagen from the aspects of extraction, processing and modification. J. Leather Sci. Eng. 2020, 2, 19. [Google Scholar] [CrossRef]
- Lee, F.H.; Shen, P.C.; Jou, I.M.; Li, C.Y.; Hsieh, J.L. A Population-Based 16-Year Study on the Risk Factors of Surgical Site Infection in Patients after Bone Grafting: A Cross-Sectional Study in Taiwan. Medicine 2015, 94, e2034. [Google Scholar] [CrossRef]
- Vicaretti, M. Pathophysiology of Vascular Graft Infections. In Mechanisms of Vascular Disease: A Reference Book for Vascular Specialists [Internet]; Fitridge, R., Thompson, M., Eds.; University of Adelaide Press: Adelaide, Australia, 2011; Volume 29. Available online: https://www.ncbi.nlm.nih.gov/books/NBK534262/ (accessed on 23 December 2024).
- Cieplik, F.; Rupp, C.M.; Hirsch, S.; Muehler, D.; Enax, J.; Meyer, F.; Hiller, K.-A.; Buchalla, W. Ca2+ release and buffering effects of synthetic hydroxyapatite following bacterial acid challenge. BMC Oral Health 2020, 20, 85. [Google Scholar] [CrossRef]
- Huang, J.; Cheng, Y.; Wu, Y.; Shi, X.; Du, Y.; Deng, H. Chitosan/tannic acid bilayers layer-by-layer deposited cellulose nanofibrous mats for antibacterial application. Int. J. Biol. Macromol. 2019, 139, 191–198. [Google Scholar] [CrossRef]
- Coombs, K.; Rodriguez-Quijada, C.; Clevenger, J.O.; Sauer-Budge, A.F. Current Understanding of Potential Linkages between Biocide Tolerance and Antibiotic Cross-Resistance. Microorganisms 2023, 11, 2000. [Google Scholar] [CrossRef]
- Sehmi, S.K.; Allan, E.; MacRobert, A.J.; Parkin, I. The bactericidal activity of glutaraldehyde-impregnated polyurethane. MicrobiologyOpen 2016, 5, 891–897. [Google Scholar] [CrossRef]
- Hopwood, D. The reactions of glutaraldehyde with nucleic acids. Histochem. J. 1975, 7, 267–276. [Google Scholar] [CrossRef]
- Zhang, Q.; Zhang, J.; Zhang, J.; Xu, D.; Li, Y.; Liu, Y.; Zhang, X.; Zhang, R.; Wu, Z.; Weng, P. Antimicrobial Effect of Tea Polyphenols against Foodborne Pathogens: A Review. J. Food Prot. 2021, 84, 1801–1808. [Google Scholar] [CrossRef]
- Lobiuc, A.; Pavăl, N.-E.; Mangalagiu, I.I.; Gheorghiță, R.; Teliban, G.-C.; Amăriucăi-Mantu, D.; Stoleru, V. Future Antimicrobials: Natural and Functionalized Phenolics. Molecules 2023, 28, 1114. [Google Scholar] [CrossRef]
- Othman, L.; Sleiman, A.; Abdel-Massih, R.M. Antimicrobial Activity of Polyphenols and Alkaloids in Middle Eastern Plants. Front. Microbiol. 2019, 10, 911. [Google Scholar] [CrossRef]

| Sample Code | Coll/HAp 3:1 Mineralized Gel | Coll/HAp 1:1 Mineralized Gel | Glutaraldehyde 0.2% | Tannic Acid 1% | Genipin 1.5% |
|---|---|---|---|---|---|
| I.1 | 9 mL | - | - | - | - |
| I.2 | 9 mL | - | 1 mL | - | - |
| I.3 | 9 mL | - | - | 1 mL | - |
| I.4 | 9 mL | - | - | - | 1 mL |
| II.1 | - | 9 mL | - | - | - |
| II.2 | - | 9 mL | 1 mL | - | - |
| II.3 | - | 9 mL | - | 1 mL | - |
| II.4 | - | 9 mL | - | - | 1 mL |
| Element | Weight % | Atomic % | Error % |
|---|---|---|---|
| C K | 22.63 | 33.83 | 12.54 |
| O K | 43.26 | 48.55 | 11.18 |
| Na K | 3.03 | 2.37 | 14.86 |
| P K | 9.08 | 5.26 | 5.4 |
| Cl K | 2.17 | 1.1 | 7.23 |
| Ca K | 19.83 | 8.88 | 2 |
| Sample | Mass Loss % RT-135 °C | Endo I °C | Mass Loss % 135–400 °C | Mass Loss % 400–900 °C | Residual Mass % | HAp % (rez 92%) |
|---|---|---|---|---|---|---|
| I.1 | 8.70 | 72.1 | 38.73 | 33.69 | 18.88 | 20.52 |
| I.2 | 7.82 | 71.4 | 39.56 | 33.16 | 19.41 | 21.10 |
| I.3 | 6.93 | 74.7 | 38.78 | 34.18 | 20.09 | 21.84 |
| I.4 | 9.82 | 84.8 | 36.60 | 35.63 | 17.94 | 19.50 |
| Sample | Mass Loss % RT-135 °C | Endo I °C | Mass Loss % 135–400 °C | Mass Loss % 400–900 °C | Residual Mass % | HAp % (rez 92%) |
|---|---|---|---|---|---|---|
| II.1 | 6.91 | 79.0 | 32.89 | 19.79 | 40.41 | 43.92 |
| II.2 | 8.63 | 78.6 | 33.24 | 18.20 | 39.92 | 43.39 |
| II.3 | 7.65 | 75.1 | 33.77 | 18.85 | 39.72 | 43.17 |
| II.4 | 7.92 | 80.5 | 33.37 | 19.40 | 39.27 | 42.68 |
| Sample | Result | |
|---|---|---|
| Escherichia coli ATCC 10536 | Staphylococcus aureus ATCC 6538 | |
| I.1 | + | + |
| II.1 | ++ | +++ |
| I.2 | ++ | ++ |
| II.2 | +++ | +++ |
| I.3 | +++ | +++ |
| II.3 | +++ | +++ |
| I.4 | +++ | +++ |
| II.4 | +++ | +++ |
Disclaimer/Publisher’s Note: The statements, opinions and data contained in all publications are solely those of the individual author(s) and contributor(s) and not of MDPI and/or the editor(s). MDPI and/or the editor(s) disclaim responsibility for any injury to people or property resulting from any ideas, methods, instructions or products referred to in the content. |
© 2025 by the authors. Licensee MDPI, Basel, Switzerland. This article is an open access article distributed under the terms and conditions of the Creative Commons Attribution (CC BY) license (https://creativecommons.org/licenses/by/4.0/).
Share and Cite
Vladu, A.F.; Albu Kaya, M.G.; Truşcă, R.D.; Motelica, L.; Surdu, V.-A.; Oprea, O.C.; Constantinescu, R.R.; Cazan, B.; Ficai, D.; Andronescu, E.; et al. The Role of Crosslinking Agents in the Development of Collagen–Hydroxyapatite Composite Materials for Bone Tissue Engineering. Materials 2025, 18, 998. https://doi.org/10.3390/ma18050998
Vladu AF, Albu Kaya MG, Truşcă RD, Motelica L, Surdu V-A, Oprea OC, Constantinescu RR, Cazan B, Ficai D, Andronescu E, et al. The Role of Crosslinking Agents in the Development of Collagen–Hydroxyapatite Composite Materials for Bone Tissue Engineering. Materials. 2025; 18(5):998. https://doi.org/10.3390/ma18050998
Chicago/Turabian StyleVladu, Alina Florentina, Madalina Georgiana Albu Kaya, Roxana Doina Truşcă, Ludmila Motelica, Vasile-Adrian Surdu, Ovidiu Cristian Oprea, Rodica Roxana Constantinescu, Bogdan Cazan, Denisa Ficai, Ecaterina Andronescu, and et al. 2025. "The Role of Crosslinking Agents in the Development of Collagen–Hydroxyapatite Composite Materials for Bone Tissue Engineering" Materials 18, no. 5: 998. https://doi.org/10.3390/ma18050998
APA StyleVladu, A. F., Albu Kaya, M. G., Truşcă, R. D., Motelica, L., Surdu, V.-A., Oprea, O. C., Constantinescu, R. R., Cazan, B., Ficai, D., Andronescu, E., & Ficai, A. (2025). The Role of Crosslinking Agents in the Development of Collagen–Hydroxyapatite Composite Materials for Bone Tissue Engineering. Materials, 18(5), 998. https://doi.org/10.3390/ma18050998

